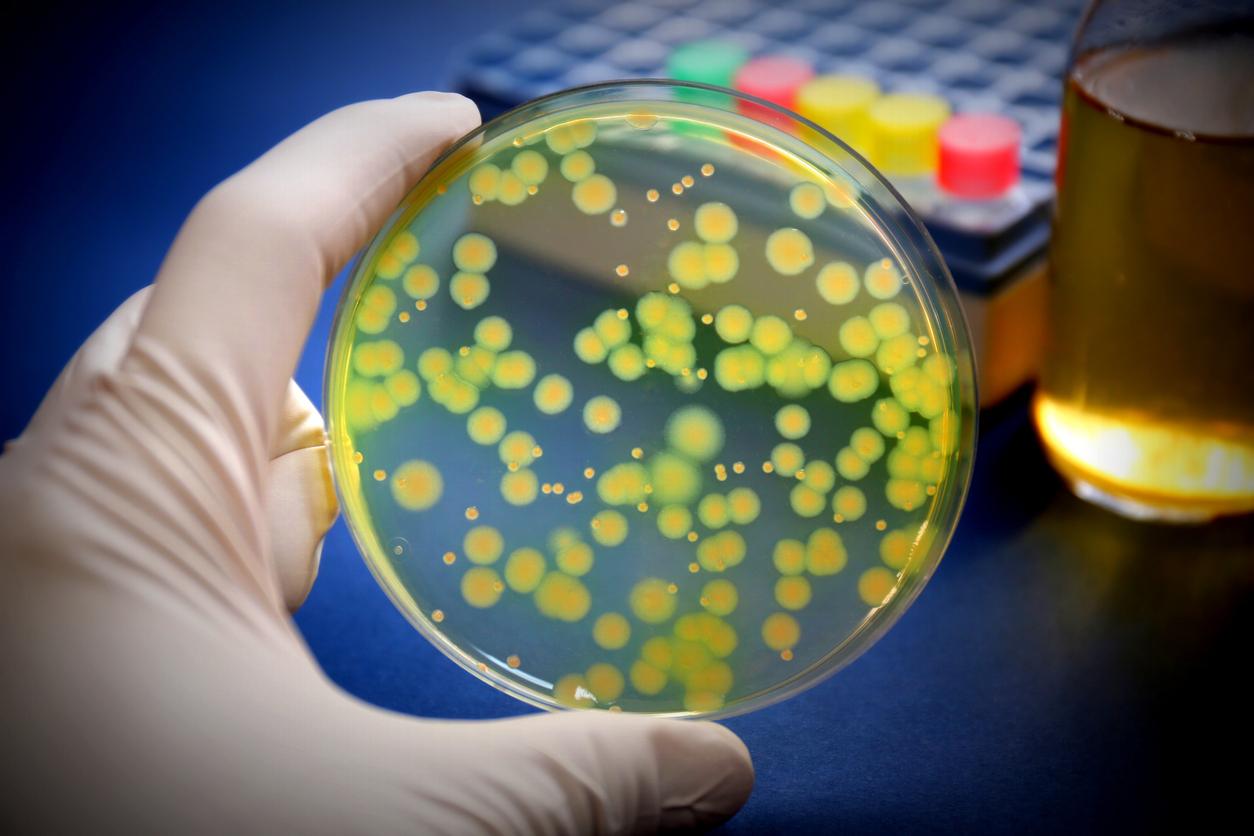
Cette bactérie se nourrit du plastique présent dans les hôpitaux

- La bactérie Pseudomonas aeruginosa est une bactérie résistante, présente dans les milieux hospitaliers.
- Elle serait capable de dégrader les plastiques pour s’en nourrir et se développer.
- Or, le matériau est omniprésent à l’hôpital, notamment dans certains implants et dans les cathéters.
Des bactéries mangeuses de plastique existent dans l’environnement. Si elles sont une option intéressante pour lutter contre la pollution, elles peuvent devenir une menace dans certains milieux. Dans la revue spécialisée Cell, des scientifiques révèlent que l’un de ces agents pathogènes, présent à l’hôpital, peut se nourrir du plastique pour se développer.
Une bactérie dangereuse, capable d’utiliser le plastique pour se développer
"Le plastique est largement utilisé dans les hôpitaux, notamment dans les sutures (en particulier celles à dissolution rapide), les pansements et les implants", rappellent les scientifiques de l’université Brunel, au Royaume-Uni. Dans leurs travaux, ils ont analysé le génome d'agents pathogènes hospitaliers pour déterminer s'ils possédaient les mêmes enzymes de dégradation du plastique que certaines bactéries présentes dans l’environnement.
"Nous avons été surpris de découvrir que certains germes hospitaliers, comme Pseudomonas aeruginosa, pourraient être capables de décomposer le plastique", révèlent-ils. Cette bactérie est considérée comme un agent pathogène hautement prioritaire par l'Organisation mondiale de la Santé : elle est responsable d'environ 559.000 décès chaque année dans le monde, et de nombreuses infections sont contractées à l’hôpital.
Comment le plastique rend la bactérie plus résistante ?
Lors de leurs travaux, ils ont découvert qu’une souche de cette bactérie est capable de dégrader le plastique et de l’utiliser comme nourriture pour se développer. Or, elle a également la capacité de créer des biofilms : ces couches la protègent du système immunitaire et des antibiotiques. "Nous avons ensuite analysé la composition du biofilm et découvert que ce pathogène produisait des biofilms plus volumineux en incluant le plastique dégradé dans cette couche visqueuse – ou ‘matrice’, comme on l'appelle officiellement, indiquent les auteurs. P. aeruginosa utilisait le plastique comme ciment pour construire une communauté bactérienne plus forte."
Bactérie mangeuse de plastique : un matériau omniprésent à l'hôpital
Ils rappellent que les agents pathogènes comme P. aeruginosa peuvent survivre longtemps dans les hôpitaux, où le plastique est omniprésent. Le matériau est utilisé pour les implants orthopédiques, les cathéters, les implants dentaires et même dans les compresses en hydrogel utilisées pour soigner les brûlures. "Cette persistance dans les hôpitaux pourrait-elle être due à la capacité des agents pathogènes à ingérer le plastique ? Nous pensons que c’est une possibilité réelle", indiquent-ils. À terme, cela pourrait nuire à l’efficacité de certains traitements ou aggraver l’état des patients. "Heureusement, les scientifiques travaillent sur des solutions, comme l’ajout de substances antimicrobiennes aux plastiques médicaux pour empêcher les germes de s’en nourrir, préviennent ces scientifiques. Mais maintenant que nous savons que certains germes peuvent dégrader le plastique, nous devons en tenir compte lors du choix des matériaux destinés à un usage médical."